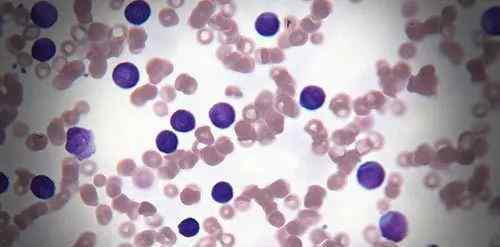

近年来,在医院的性病门诊中,念珠菌性阴道炎患者的数量呈上升趋势,在孕妇、糖尿病患者和接受大量雌激素治疗的患者中更为常见。

据统计,中国约75%的女性一生中至少患过一次念珠菌性阴道炎,而45%的女性患过两次以上念珠菌性阴道炎。

什么是念珠菌阴道炎?
念珠菌阴道炎,原名霉菌性阴道炎,是由念珠菌引起的一种阴道炎,最常见的病原体是白色念珠菌。10%~20%的正常女性阴道内可能有少量白色念珠菌,但不引起症状。只有当身体抵抗力下降,念珠菌达到相当数量时,才能致病。
当阴道内糖原增多,酸度增加,局部细胞免疫力下降时,适用于念珠菌繁殖引起的炎症。但在孕妇中,阴道上皮的糖原含量会明显增加,从而导致阴道酸度增强,从而为念珠菌繁殖提供有利条件。因此,孕妇酒渣鼻阴道炎的发病率明显高于非孕妇。
念珠菌阴道炎的症状
外阴和阴道念珠菌的增生可引起局部炎症,使患者感到外阴灼热、发热和瘙痒。严重者,外阴、肛门周围、大腿根部、腹股沟区大面积红肿。

但念珠菌性阴道炎引起的瘙痒时轻时重,有时会出现。瘙痒严重时,人就睡不着觉,严重影响正常工作生活。
除了外阴瘙痒,念珠菌性阴道炎的女性经常会发现白带像豆腐渣一样,小便时还会感觉尿道口疼痛烧灼感,而阴道红肿则使性交疼痛。
念珠菌性阴道炎的危害
01,导致不孕不育
阴道pH值的变化会抑制精子运动,炎症细胞会吞噬精子,削弱精子运动能力。此外,炎症发生时的性疼痛和性欲丧失会影响怀孕。但念珠菌性阴道炎引起的不孕是暂时性的,治愈后仍可受孕。

02.影响胎儿发育
孕妇患病后,极少数人阴道内的念珠菌会通过子宫颈上行,穿透胎膜感染胎儿,造成早产。此外,胎儿经母亲阴道分娩时,也可能感染念珠菌,常引起口腔念珠菌病。
03.影响生活质量
患有念珠菌性阴道炎,会伴有外阴瘙痒等症状,给女性带来诸多不便和影响,也会影响夫妻生活,甚至会感染家人。

04、引起其他疾病
如果念珠菌性阴道炎长期不治疗,很容易引起炎症和宫颈炎。
念珠菌阴道炎的预防
01、注意生活习惯
不要穿太紧身的衣服,不要有卫生的如厕习惯,不要经常作息,不要吃太多烧烤或味道太重的食物等。,这些都有助于治愈阴道炎,避免复发。

02、不要洗太多
不要经常冲洗阴道,这样容易破坏阴道环境,造成菌群失调。
03、谨慎用药
不要随便吃抗生素,提高免疫力,少吃甜食,多喝酸奶。具有治疗性质的生物制剂,如含有嗜酸乳酸菌的乳制品,可以预防感染而无明显副作用,从而减少对抗真菌药物的依赖。

04、性伴侣同时治疗
建议同时治疗患病女性及其性伴侣,因为患者的性伴侣在其口腔、精液和阴茎冠沟有一定比例的阳性率。
念珠菌性阴道炎是一种很难治疗的疾病,它的很多症状和很多疾病症状是一样的,很容易复发,应该引起女性的重视。
1.《念珠菌阳性 念珠菌性阴道炎可怕吗?女人一辈子都不想要它!》援引自互联网,旨在传递更多网络信息知识,仅代表作者本人观点,与本网站无关,侵删请联系页脚下方联系方式。
2.《念珠菌阳性 念珠菌性阴道炎可怕吗?女人一辈子都不想要它!》仅供读者参考,本网站未对该内容进行证实,对其原创性、真实性、完整性、及时性不作任何保证。
3.文章转载时请保留本站内容来源地址,https://www.lu-xu.com/jiaoyu/972822.html